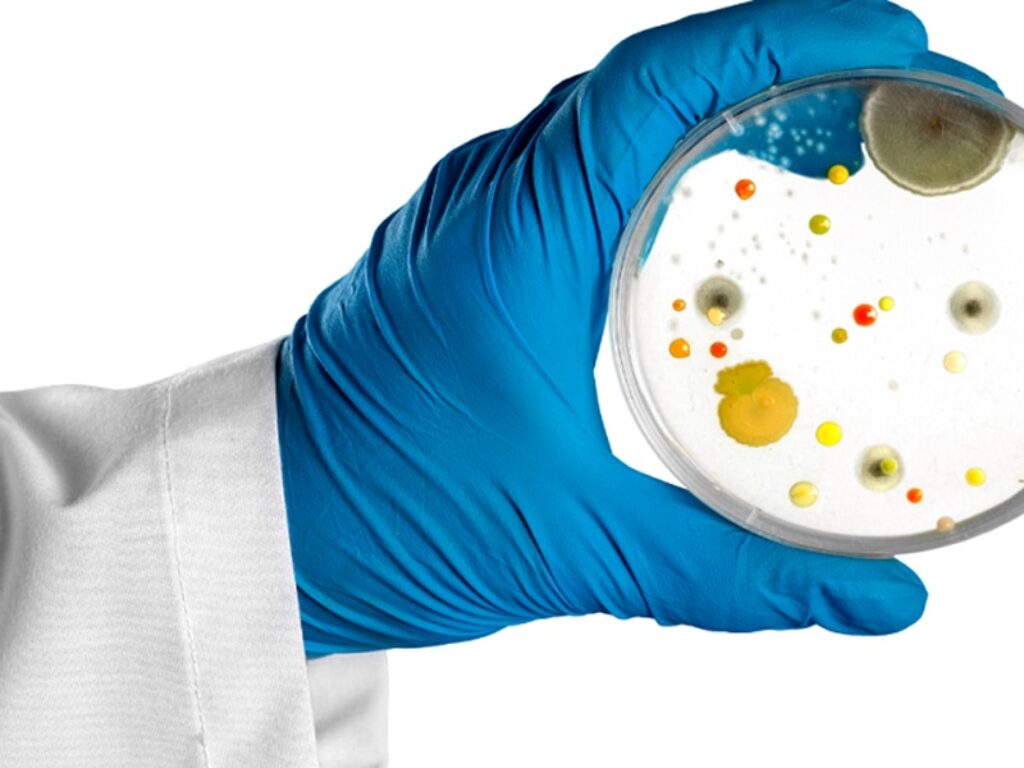

Al via il progetto RESISTIMIT, un registro dinamico e una piattaforma software contro i microbi multiresistenti agli antibiotici
I microbi multiresistenti agli antibiotici sono la nuova emergenza sanitaria con proiezioni preoccupanti.. Secondo i dati di settembre 2023 dello studio ALARICO relativi a 17 ospedali italiani le infezioni da microrganismi multiresistenti carbapenetici causano un eccesso di mortalità fino al 35%. “Il progetto si estende a 30 centri infettivologici a livello nazionale, 10 in ogni area geografica tra Nord, Centro e Sud, per un’attività di sorveglianza e la condivisione di dati attualizzati su trend epidemiologici, caratteristiche dell’infezione, mortalità associata all’infezione” spiega il Prof. Marco Falcone, Segretario SIMIT.
Entra nel vivo il progetto nazionale della piattaforma clinica Resistimit, realizzato dalla Società Italiana di Malattie Infettive e Tropicali – SIMIT per combattere i microrganismi multiresistenti agli antibiotici, fenomeno in crescita in tutta Europa, con l’Italia che è tra i Paesi con le peggiori performance.
A caratterizzare l’iniziativa sono il registro dinamico italiano sullo studio delle infezioni da germi multiresistenti, che coinvolge 30 centri infettivologici suddivisi tra Nord, Centro e Sud in un sistema di sorveglianza molto solido, e una piattaforma software per la messa in rete di questi dati, che tramite intelligenza artificiale diventeranno utile strumento anche per definire futuri scenari. Proprio per rafforzare questa rete nelle tre zone del Paese, SIMIT ha organizzato tre convegni a Roma, Napoli e Milano che favoriranno la strutturazione di questa sinergia.
A far partire Resistimit a fine 2022 sono stati dieci centri pilota, dislocati in tutte le aree del Paese: Roma con Spallanzani, Tor Vergata e Umberto I, Napoli con Cotugno e Federico II, Bari, Foggia, Palermo, Pisa, Varese, Modena, Perugia, Padova. “Il progetto ora si estende su 30 centri infettivologici a livello nazionale, dieci in ogni area geografica tra Nord, Centro e Sud – spiega il Prof. Marco Falcone, Segretario SIMIT – Queste 30 unità operative di malattie infettive svolgeranno un’attività di sorveglianza e condivideranno dati continuamente attualizzati su trend epidemiologici, caratteristiche dell’infezione, mortalità associata all’infezione e altri parametri utili. Oggetto di studio saranno batteri, funghi, virus e ogni altro microrganismo resistenti ai farmaci. I nostri centri clinici devono fornire ai decisori, compresa AIFA, un supporto tecnico-scientifico basato su dati di real-life per dimostrare efficacia e sicurezza dell’uso degli antibiotici nel nostro Paese. Gli antibiotici restano un prezioso strumento salvavita, ma devono essere usati con consapevolezza”.
Ruolo della tecnologia
Oltre alla sinergia tra i vari centri infettivologici, il progetto Resistimit si contraddistingue per la funzione innovativa degli strumenti tecnologici. “La piattaforma software che utilizzeremo permetterà non solo di mettere in rete tutti i dati di real life, ma anche di determinare un sistema di analisi dei dati stessi tramite l’intelligenza artificiale con analisi predittive – evidenzia il Prof. Marco Falcone – Ciò significa che avremo la possibilità di anticipare le diagnosi, identificare il miglior trattamento, individuare i casi più complessi, fino a migliorare la gestione delle infezioni e ridurre la mortalità. Questo trasforma la ricerca da statica a dinamica”.
Resistenza agli antibiotici, i dati
Gli ultimi dati proposti anche da OMS e ECDC confermano il trend peggiorativo dei germi multiresistenti in tutto il continente, con particolare attenzione per l’Italia. Colpisce che non siano coinvolti solo i Paesi mediterranei come in passato, ma anche quelli anglosassoni e scandinavi, con i microrganismi resistenti in rapida espansione. “L’Italia resta il primo Paese europeo per numero di infezioni e di morti, con circa 15mila decessi l’anno stimabili come causati da microrganismi resistenti agli antibiotici – evidenzia il Prof. Marco Falcone – Come indicato dai dati dell’Organizzazione Mondiale della Sanità, nel 2050 l’antibiotico-resistenza sarà la prima causa di morte a livello globale, provocando 10 milioni di decessi. Nel nostro lavoro verranno utilizzati anche i dati della rete ALARICO (Advancing knowLedge on Antimicrobial Resistant Infections Collaboration Network), i cui recenti aggiornamenti di settembre 2023 relativi a 17 ospedali italiani attestano come le infezioni da microrganismi multiresistenti carbapenetici, i più difficili da trattare, causano, rispetto ai microrganismi sensibili a questi antibiotici, un eccesso di mortalità che può arrivare fino al 35%”.
“Il progetto Resistimit, curato da un board di giovani infettivologi con una profonda esperienza sia clinica che di ricerca, è emblematico per certificare l’impegno di SIMIT contro un fenomeno quale quello dei microbi multiresistenti, caratterizzato da numeri allarmanti e dall’assenza di adeguate contromisure – sottolinea il Prof. Claudio Mastroianni, Presidente SIMIT e coordinatore del progetto insieme al Prof. Falcone – Con questo progetto si vuole fornire supporto sia ai clinici che alle istituzioni. Si affianca ai sistemi di sorveglianza ministeriali, ma si caratterizza per il valore aggiunto della gestione clinica, per la dinamicità, per gli interventi in real life. Si offre un prezioso strumento per analizzare nel dettaglio tutte le sfaccettature di questa problematica e per ottenere informazioni aggiornate sulle infezioni provocate da microrganismi multiresistenti”.